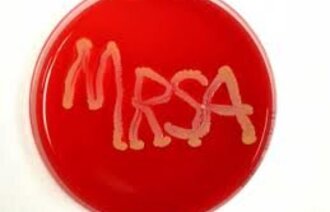

Et tiltak som virker
Forskning
Blodprøve kan forutsi demens
Nyheter
Ikke nødvendig med isolasjon
Nyheter
Friske, men har det ikke bra
Nyheter
Morgendagens overgripere sitter i klasserommet
Fagutvikling
Ingen økning til forebygging
Nyheter
Dansk samhandling
Fagutvikling
Miljøtiltak ga bedre atmosfære på DPS
Fagutvikling
Sårbare for stress
Fagutvikling
Forebygger vold med miljøterapi
Fagutvikling
Aktiv praksis i hjemmetjenesten
Fagutvikling
En dose aktivitet
Nyheter
Hun vil bygge barn
Nyheter
Annonse